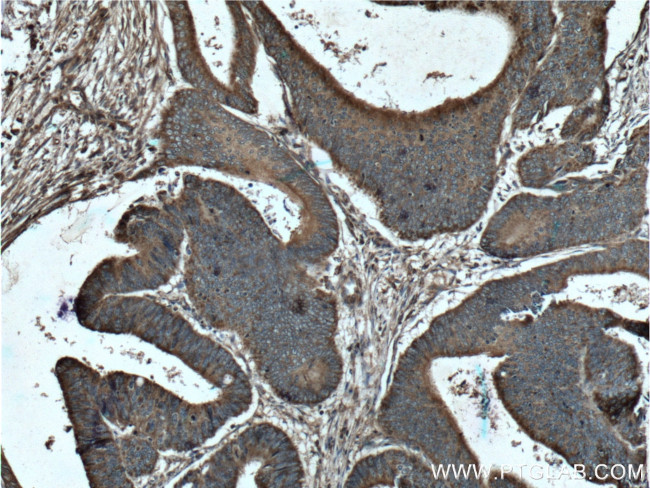
MTHFD2 Antibody in Immunohistochemistry (Paraffin) (IHC (P))

Search
Proteintech
MTHFD2 Polyclonal Antibody
{{$productOrderCtrl.translations['antibody.pdp.commerceCard.promotion.promotions']}}
{{$productOrderCtrl.translations['antibody.pdp.commerceCard.promotion.viewpromo']}}
{{$productOrderCtrl.translations['antibody.pdp.commerceCard.promotion.promocode']}}: {{promo.promoCode}} {{promo.promoTitle}} {{promo.promoDescription}}. {{$productOrderCtrl.translations['antibody.pdp.commerceCard.promotion.learnmore']}}
产品信息
12270-1-AP
种属反应
已发表种属
宿主/亚型
分类
类型
抗原
偶联物
形式
浓度
规格
纯化类型
保存液
内含物
保存条件
运输条件
产品详细信息
Immunogen sequence: MAATSLMSA LAARLLQPAH SCSLRLRPFH LAAVRNEAVV ISGRKLAQQI KQEVRQEVEE WVASGNKRPH LSVILVGENP ASHSYVLNKT RAAAVVGINS ETIMKPASIS EEELLNLINK LNNDDNVDGL LVQLPLPEHI DERRICNAVS PDKDVDGFHV INVGRMCLDQ YSMLPATPWG VWEIIKRTGI PTLGKNVVVA GRSKNVGMPI AMLLHTDGAH ERPGGDATVT ISHRYTPKEQ LKKHTILADI VISAAGIPNL ITADMIKEGA AVIDVGINRV HDPVTAKPKL VGDVDFEGVR QKAGYITPVP GGVGPMTVAM LMKNTIIAAK KVLRLEEREV LKSKELGVAT N (1-350 aa encoded by BC017054)
靶标信息
This gene encodes a nuclear-encoded mitochondrial bifunctional enzyme with methylenetetrahydrofolate dehydrogenase and methenyltetrahydrofolate cyclohydrolase activities. The enzyme functions as a homodimer and is unique in its absolute requirement for magnesium and inorganic phosphate. Formation of the enzyme-magnesium complex allows binding of NAD. Alternative splicing results in two different transcripts, one protein-coding and the other not protein-coding. This gene has a pseudogene on chromosome 7.
仅用于科研。不用于诊断过程。未经明确授权不得转售。
生物信息学
蛋白别名: Bifunctional methylenetetrahydrofolate dehydrogenase/cyclohydrolase, mitochondrial; methylenetetrahydrofolate dehydrogenase (NAD+ dependent), methenyltetrahydrofolate cyclohydrolase; methylenetetrahydrofolate dehydrogenase 2; NAD-dependent methylene tetrahydrofolate dehydrogenase cyclohydrolase; unnamed protein product
基因别名: AW558851; MTHFD2; NMDMC
UniProt ID: (Human) P13995, (Mouse) P18155
Entrez Gene ID: (Human) 10797, (Mouse) 17768, (Rat) 680308